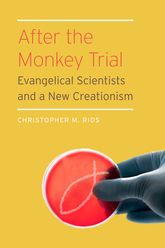
rios

Is the sky falling for progressives like me? In The Atlantic, journalist Molly Ball argues that liberals are losing the culture wars. The same topic just came up in our recent panel of educational historians. Is Ball right?
She looked at the results of the recent mid-term elections. In Ohio, voters rejected recreational marijuana. In Houston, they voted against gender-neutral bathrooms. In San Francisco, they booted an immigration-friendly sheriff. In Virginia, gun control struggled. In Kentucky, Kim Davis’s brand of in-your-face culture-war bluster helped win the governor’s office.
Ball’s conclusion?
taken together these results ought to inspire caution among liberals who believe their cultural views are widely shared and a recipe for electoral victory.
Fair enough. But not surprisingly, our all-star panel of historians came to different conclusions. To historians, these electoral losses don’t seem so cataclysmic. After all, consider the historical context: people are voting about making pot legal. Can you really deny Andrew Hartman’s argument that the echoes of the 1960s are dominated by the accents of hippies?
And yes, Houston lost its push for bathrooms that recognize the fluidity of gender. But look again: Who lost? The city in Texas with the openly gay mayor, that’s who.
We can make the same case for the other elections as well. Yes, conservatives here and there will have some successes in blocking the progressive changes that continue to roll through our society. Such blocking maneuvers, however, are a rearguard action.
Voting against gender-neutral bathrooms does not change the fact that we are now considering gender-neutral bathrooms. Thirty years ago—heck, even five years ago—that would not have been up for debate.
I think we need a more nuanced answer to the question of winning and losing when it comes to our culture wars. In my recent book, I looked at the educational activism of conservatives during the twentieth century. A lot of the time, they won. But just as with these recent cases, conservatives tended to succeed only in blocking or delaying certain limited sections of progressive change. Progressives still set the cultural agenda.
Here’s my two cents: first of all, I agree with our dean of educational historians, Jon Zimmerman. Jon argued this week that it is mostly meaningless to talk about winning or losing in this context. As does this Atlantic article, talk about winning or losing is usually a tactic to rally the faithful of each side, not a clear-headed analysis of shifting cultural trends.
Having said that, I think we can discern a century-long trend with these sorts of fights. In every case, conservatives might win or lose the specific battle. They do not win the war. What they do win, time after time, is the right to be listened to, the right to be considered part of the conversation about these issues.
For progressives like me and most of my friends, progressive change seems like an obviously good idea. Of course people should be able to smoke pot if they want. Of course transgender people should be able to use appropriate bathrooms. Of course guns should be controlled, immigrants welcomed, and same-sex marriage rights should be honored.
When we see election results like this one, though, we are reminded that not everyone agrees with us. When we see how strongly people disagree, we should not tear our hair and gnash our teeth. We should not lament the narrow-mindedness of our fellow citizens.
Rather, we should recognize the vast differences between Americans when it comes to these issues. As we do here at ILYBYGTH, we should do our best to understand and even sympathize with those voters who disagree with us.
After all, the only real victory in our bitter culture wars will come when we can respect those with whom we disagree.